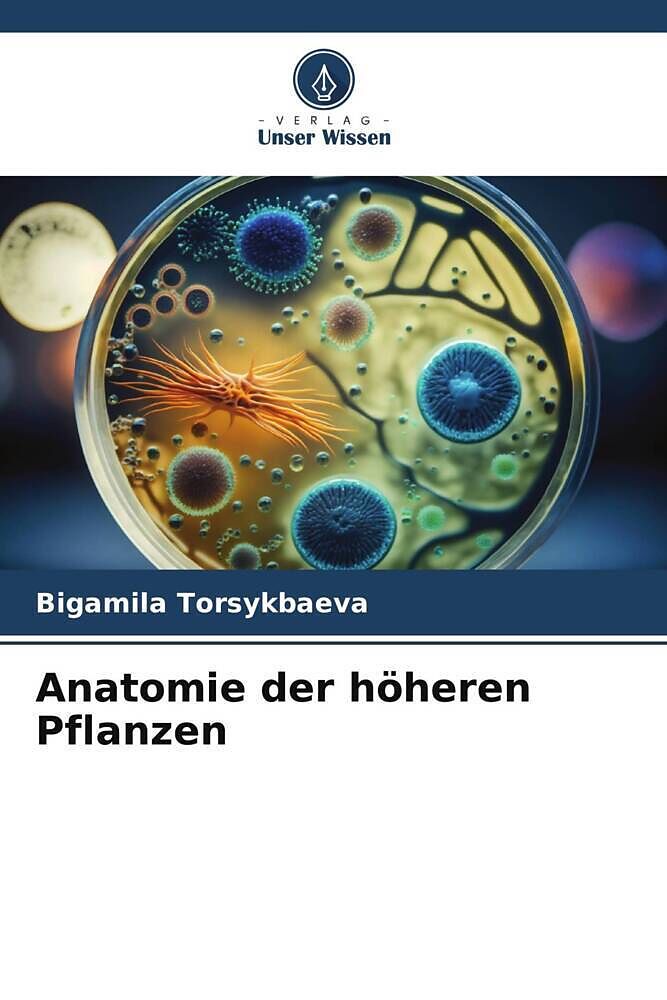

Willkommen. Schön, sind Sie da!
0

Anatomie der höheren Pflanzen
Beschreibung
Dieses Lehrbuch wurde für Studierende pharmazeutischer und landwirtschaftlicher Fachrichtungen an Universitäten zusammengestellt. Botanik ist eine grundlegende Disziplin für pharmazeutische und landwirtschaftliche Fachrichtungen. Dies bestimmte hauptsächlich d...Format auswählen
- Kartonierter EinbandCHF 107.60
Kartonierter Einband
CHF107.60
TIEFPREIS
CHF107.60
Print on Demand - Exemplar wird für Sie besorgt.
Kostenlose Lieferung
